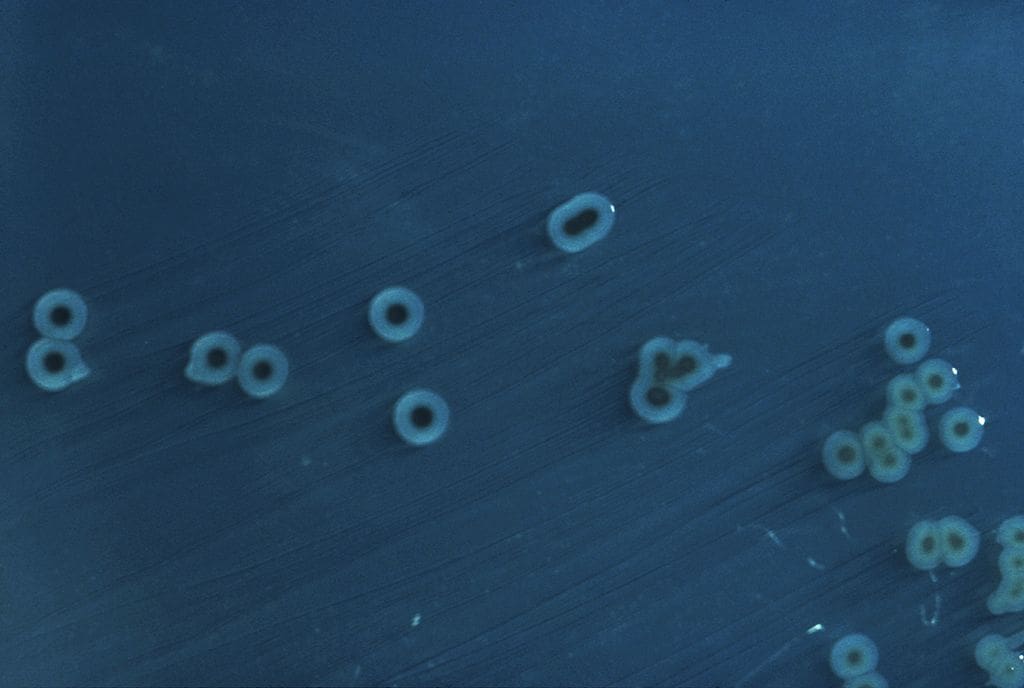

Climate change drives rise in stillbirths and newborn deaths in AfricaScience
Adrian AlexandreSeptember 3, 2024
Full article
Climate change drives rise in stillbirths and newborn deaths in Africa
A recent study published in Nature Medicine highlights a disturbing correlation between rising temperatures in sub-Saharan Africa and an increased risk of perinatal deaths. The…

California droughts amplify dangerous Valley fever surgesScience
Adrian AlexandreSeptember 3, 2024
Full article
California droughts amplify dangerous Valley fever surges
Valley fever, a fungal disease caused by Coccidioides spores, has seen a dramatic rise in cases across California, U.S. in recent decades. A new study,…

Experimental drug shows promise in protecting against air pollution-related Alzheimer’s disease in miceNewsScience
Adrian AlexandreSeptember 3, 2024
Full article
Experimental drug shows promise in protecting against air pollution-related Alzheimer’s disease in mice
A recent study by researchers at the University of Southern California (USC) has demonstrated that an experimental drug could potentially protect against the detrimental effects…

Nearly half a billion children endure increasingly extreme heat, warns UNICEFClimate
Adrian AlexandreSeptember 3, 2024
Full article
Nearly half a billion children endure increasingly extreme heat, warns UNICEF
A new UNICEF analysis has revealed that one in five children worldwide - approximately 466 million - now live in regions experiencing at least twice…

Survey reveals gaps in understanding of biodiversity loss among environmental students worldwide
Adrian AlexandreSeptember 2, 2024
Full article
Survey reveals gaps in understanding of biodiversity loss among environmental students worldwide
A global survey conducted by Goethe University Frankfurt has uncovered concerning knowledge gaps among students of environment-related subjects about the causes of biodiversity loss. The…

New study reveals hidden risks to global water security linked to rainfall originsScience
Adrian AlexandreSeptember 2, 2024
Full article
New study reveals hidden risks to global water security linked to rainfall origins
Stockholm University researchers have unveiled an alternative approach to assessing global water scarcity, revealing that the risks to water supply are more significant than previously…

Heatwaves disorient bumblebees, threatening pollinationScience
Adrian AlexandreSeptember 2, 2024
Full article
Heatwaves disorient bumblebees, threatening pollination
Rising global temperatures are not only taking a toll on human health but also profoundly affecting ecosystems, particularly the essential role of pollinators Recent research…

Global South cities face higher heat risks due to lack of green spacesClimate
Adrian AlexandreSeptember 2, 2024
Full article
Global South cities face higher heat risks due to lack of green spaces
A recent study reveals that cities in the Global South are significantly more vulnerable to extreme heat due to a shortage of cooling green spaces…

Africa faces escalating climate costs and intensifying impactsClimate
Adrian AlexandreSeptember 2, 2024
Full article
Africa faces escalating climate costs and intensifying impacts
Africa is grappling with a growing climate crisis, enduring severe impacts and shouldering disproportionate costs for necessary adaptation measures. According to a recent World Meteorological…

New model enhances accuracy of flash flood predictionsScience
Adrian AlexandreAugust 30, 2024
Full article
New model enhances accuracy of flash flood predictions
An international team of climate scientists has developed a new approach that offers significant advancements in predicting life-threatening flash floods triggered by extreme rainfall. This…

The crucial role of Atlantic-Arctic water mixing in global ocean circulation and climate stabilityClimate
Adrian AlexandreAugust 30, 2024
Full article
The crucial role of Atlantic-Arctic water mixing in global ocean circulation and climate stability
A recent study has highlighted the significant impact of mixing Atlantic and Arctic waters on sustaining the Atlantic Meridional Overturning Circulation (AMOC), a critical component…

Emerging markets’ financial sector faces urgent climate financing gaps, World Bank report revealsNews
Adrian AlexandreAugust 30, 2024
Full article
Emerging markets’ financial sector faces urgent climate financing gaps, World Bank report reveals
A new World Bank report reveals that nearly 60% of banks in Emerging Market and Developing Economies (EMDEs) allocate less than 5% of their lending…

How climate change is impacting global food and timber supply competitionClimate
Adrian AlexandreAugust 29, 2024
Full article
How climate change is impacting global food and timber supply competition
Climate change is set to significantly disrupt the global balance between land used for food production and timber harvesting, according to a new study by…
Climate change fuels rise in salmonella risk from raw produceScience
Adrian AlexandreAugust 29, 2024
Full article
Climate change fuels rise in salmonella risk from raw produce
Climate change is poised to elevate the risk of foodborne illnesses caused by Salmonella enterica, particularly through the consumption of raw produce, according to new…

Weathering the storm: the influence of rain on sea turtle hatchlingsClimate
Adrian AlexandreAugust 29, 2024
Full article
Weathering the storm: the influence of rain on sea turtle hatchlings
Sea turtles, after laying their eggs and covering them with sand, leave their offspring to develop and hatch without any parental care. The odds of…

Advancements in chemical plastics recycling pave the way for high-quality sustainable productsScience
Adrian AlexandreAugust 29, 2024
Full article
Advancements in chemical plastics recycling pave the way for high-quality sustainable products
Scientists at ETH Zurich have made significant strides in chemical recycling, a process poised to transform plastic waste management by producing high-quality products from discarded…

Killer pesticides linked to alarming decline in America’s wild beesScience
Adrian AlexandreAugust 28, 2024
Full article
Killer pesticides linked to alarming decline in America’s wild bees
A new study published in Nature Sustainability by a team of international researchers, including scientists from the University of Southern California (USC) Dornsife College, has…

Limits to underground CO₂ storage challenge climate goals, study findsScience
Adrian AlexandreAugust 28, 2024
Full article
Limits to underground CO₂ storage challenge climate goals, study finds
New research reveals significant challenges in scaling up carbon storage technologies necessary to limit global warming. A recent study led by Imperial College London has…

European Green Deal faces uncertainty as political winds shift right in the EUClimate
Adrian AlexandreAugust 28, 2024
Full article
European Green Deal faces uncertainty as political winds shift right in the EU
Once hailed as a landmark initiative to make Europe the first climate-neutral continent by 2050, the European Green Deal is encountering significant challenges as political…

Coastal cities must accelerate adaptation efforts to tackle climate changeClimate
Adrian AlexandreAugust 28, 2024
Full article
Coastal cities must accelerate adaptation efforts to tackle climate change
Coastal cities, crucial to the global economy and societal functions, are increasingly vulnerable to the effects of climate change, necessitating rapid and comprehensive adaptation measures.…

Ancient viruses locked in glacier reveal clues about Earth’s climate historyScience
Adrian AlexandreAugust 27, 2024
Full article
Ancient viruses locked in glacier reveal clues about Earth’s climate history
Study uncovers nearly 1,700 viral species in ice cores, linking viral evolution to past climate changes. A new study has unveiled the potential of ancient…

New fisheries technologies deepen gender inequalityClimate
Adrian AlexandreAugust 27, 2024
Full article
New fisheries technologies deepen gender inequality
Millions of women employed in the global fisheries industry are being sidelined as new technologies, designed to counter the effects of climate change and economic…

Microscopic fossils unlock secrets of ancient climate change and its modern parallelsScience
Adrian AlexandreAugust 27, 2024
Full article
Microscopic fossils unlock secrets of ancient climate change and its modern parallels
Recent research led by geologists at the University of Utah sheds light on how ancient climate change, occurring 50 million years ago, can inform our…

Denmark and EU push for stronger partnerships with Africa in new strategyNews
Adrian AlexandreAugust 27, 2024
Full article
Denmark and EU push for stronger partnerships with Africa in new strategy
Denmark, in collaboration with the European Union, is set to deepen its engagement with African countries, emphasizing equal partnerships and aligning with the continent's aspirations.…